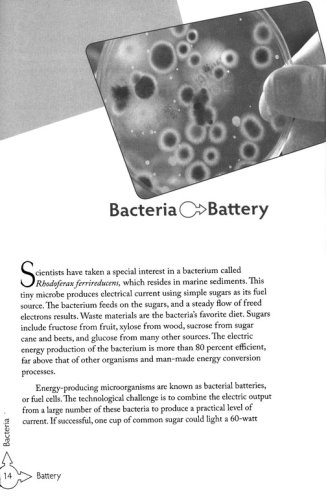

Discovery of Design: Searching Out the Creator's Secrets

- ISBN: 0890515743, 9780890515747
- Page count: 233
- Published: 2009-10-31
- Format: Paperback
- Publisher: Master Books
- Language:
- Author: Dr. Donald DeYoung
Researchers are looking to the natural world for inspiration in their designs-and creating extraordinary breakthroughs that benefit our quality of life. In a fun look at the intersections between nature and technology, learn how things like batteries, organ repair, microlenses, automotive engineering, paint, and even credit card security have links to natural designs.
Short, two-page overviews make the connection in a paragraph or two, and are followed by a reference with questions for further discussion. Lessons are arranged by category: find out how microorganisms, the insect world, flight, underwater life, land animals, people, vegetation, and nonliving objects have all contributed to the things we have in our world today! 232 pages with index, glossary, and question answer key; softcover.
Get the Book
-
 Amazon.com
$5.99
ebook
Amazon.com
$5.99
ebook
-
 Christianbook.com
From $10.74
Christianbook.com
From $10.74
-
 Amazon.com
From $14.99
Amazon.com
From $14.99
-
 Barnes&Noble.com
From $14.99
Barnes&Noble.com
From $14.99
Review Discovery of Design: Searching Out the Creator's Secrets.